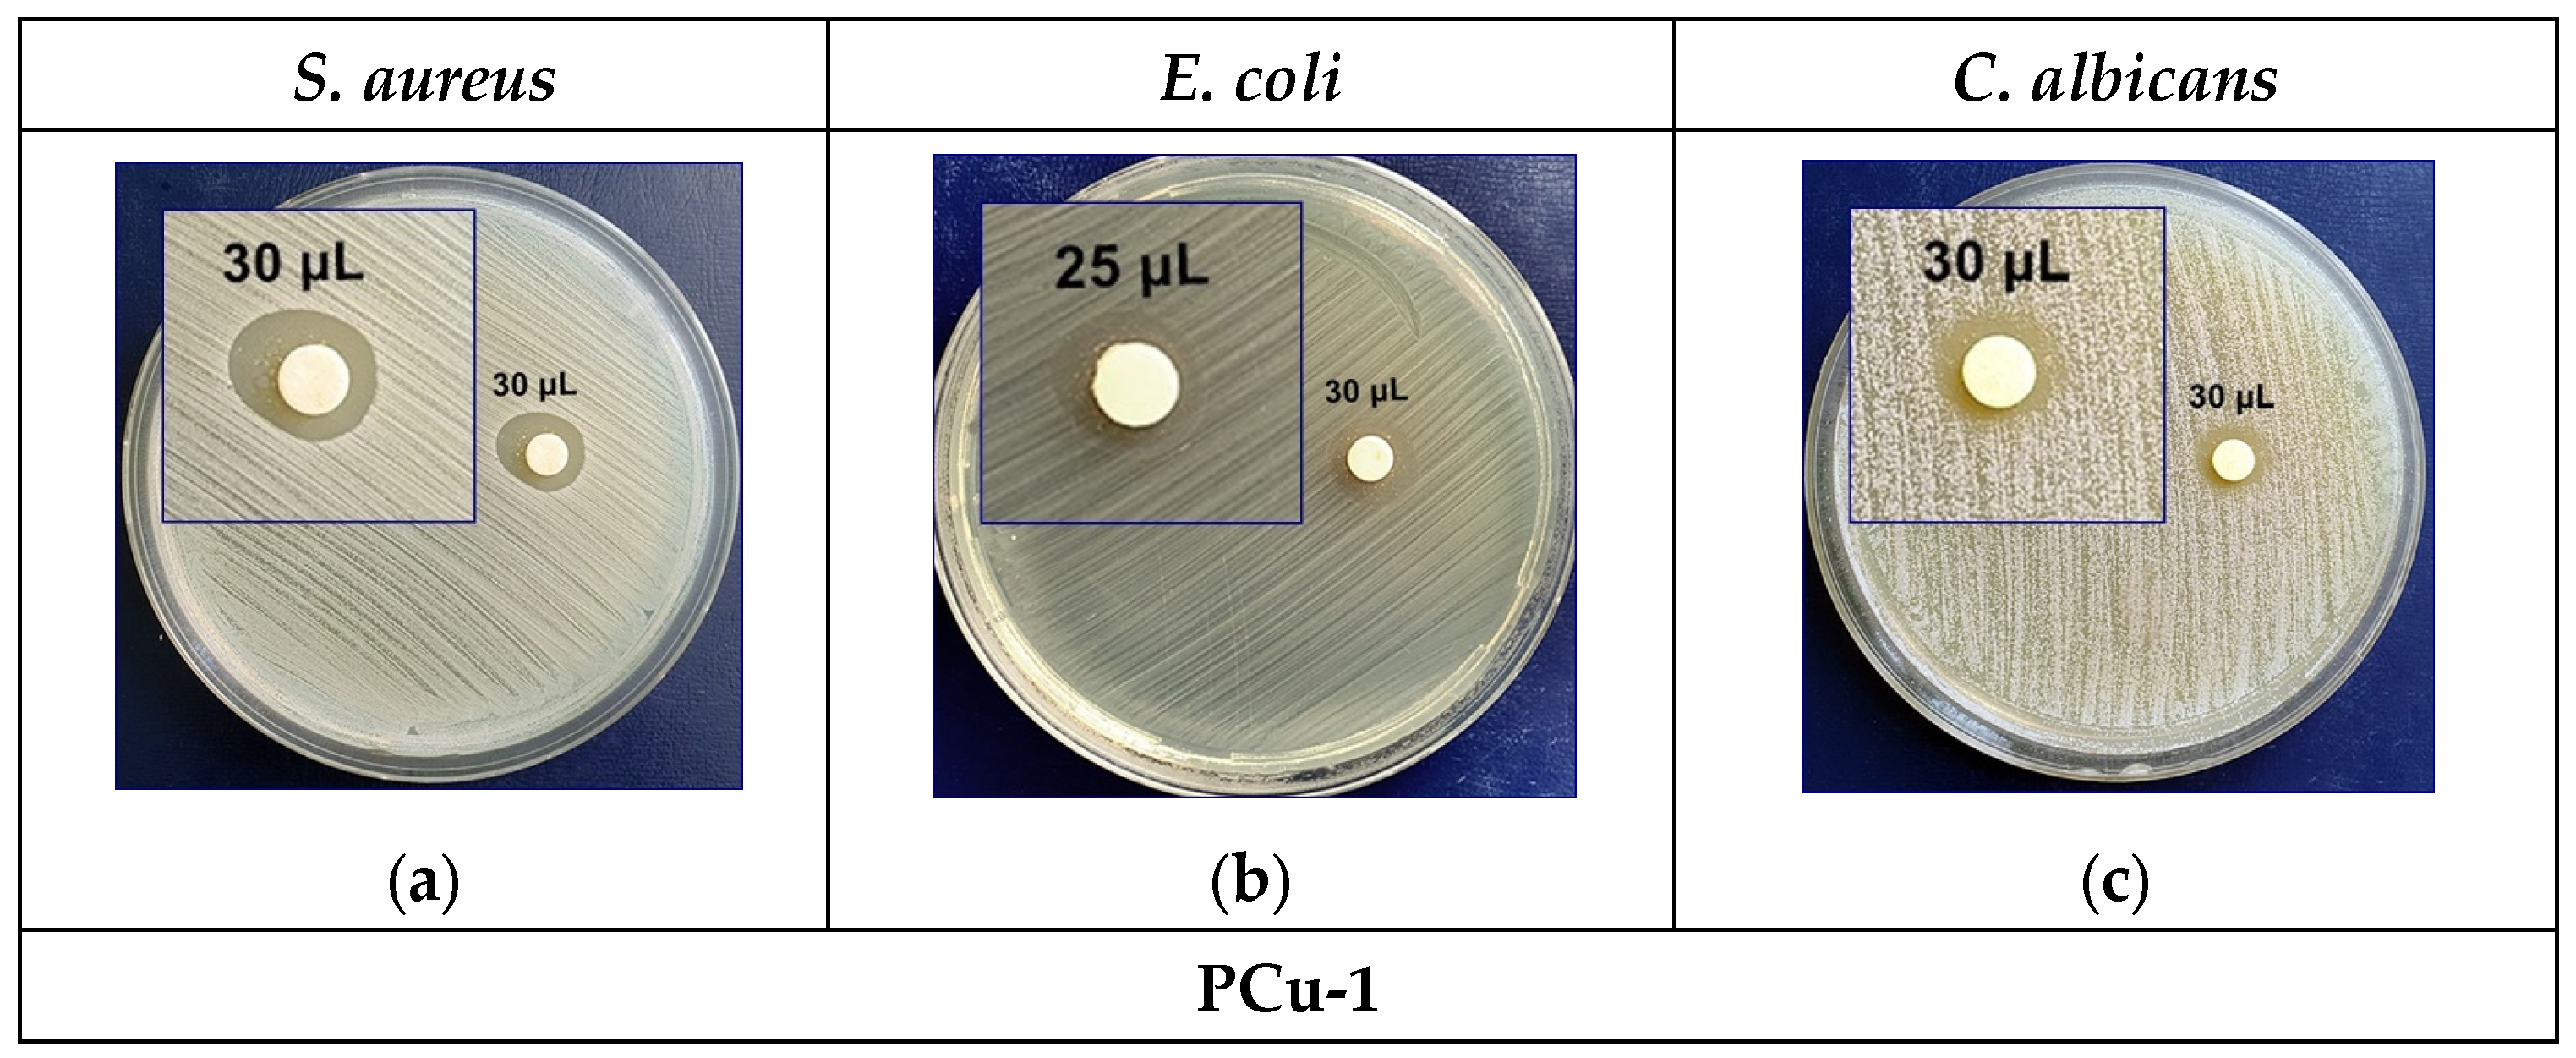
Crystals 14 00659 g011a Crystals 14 00659 g011a
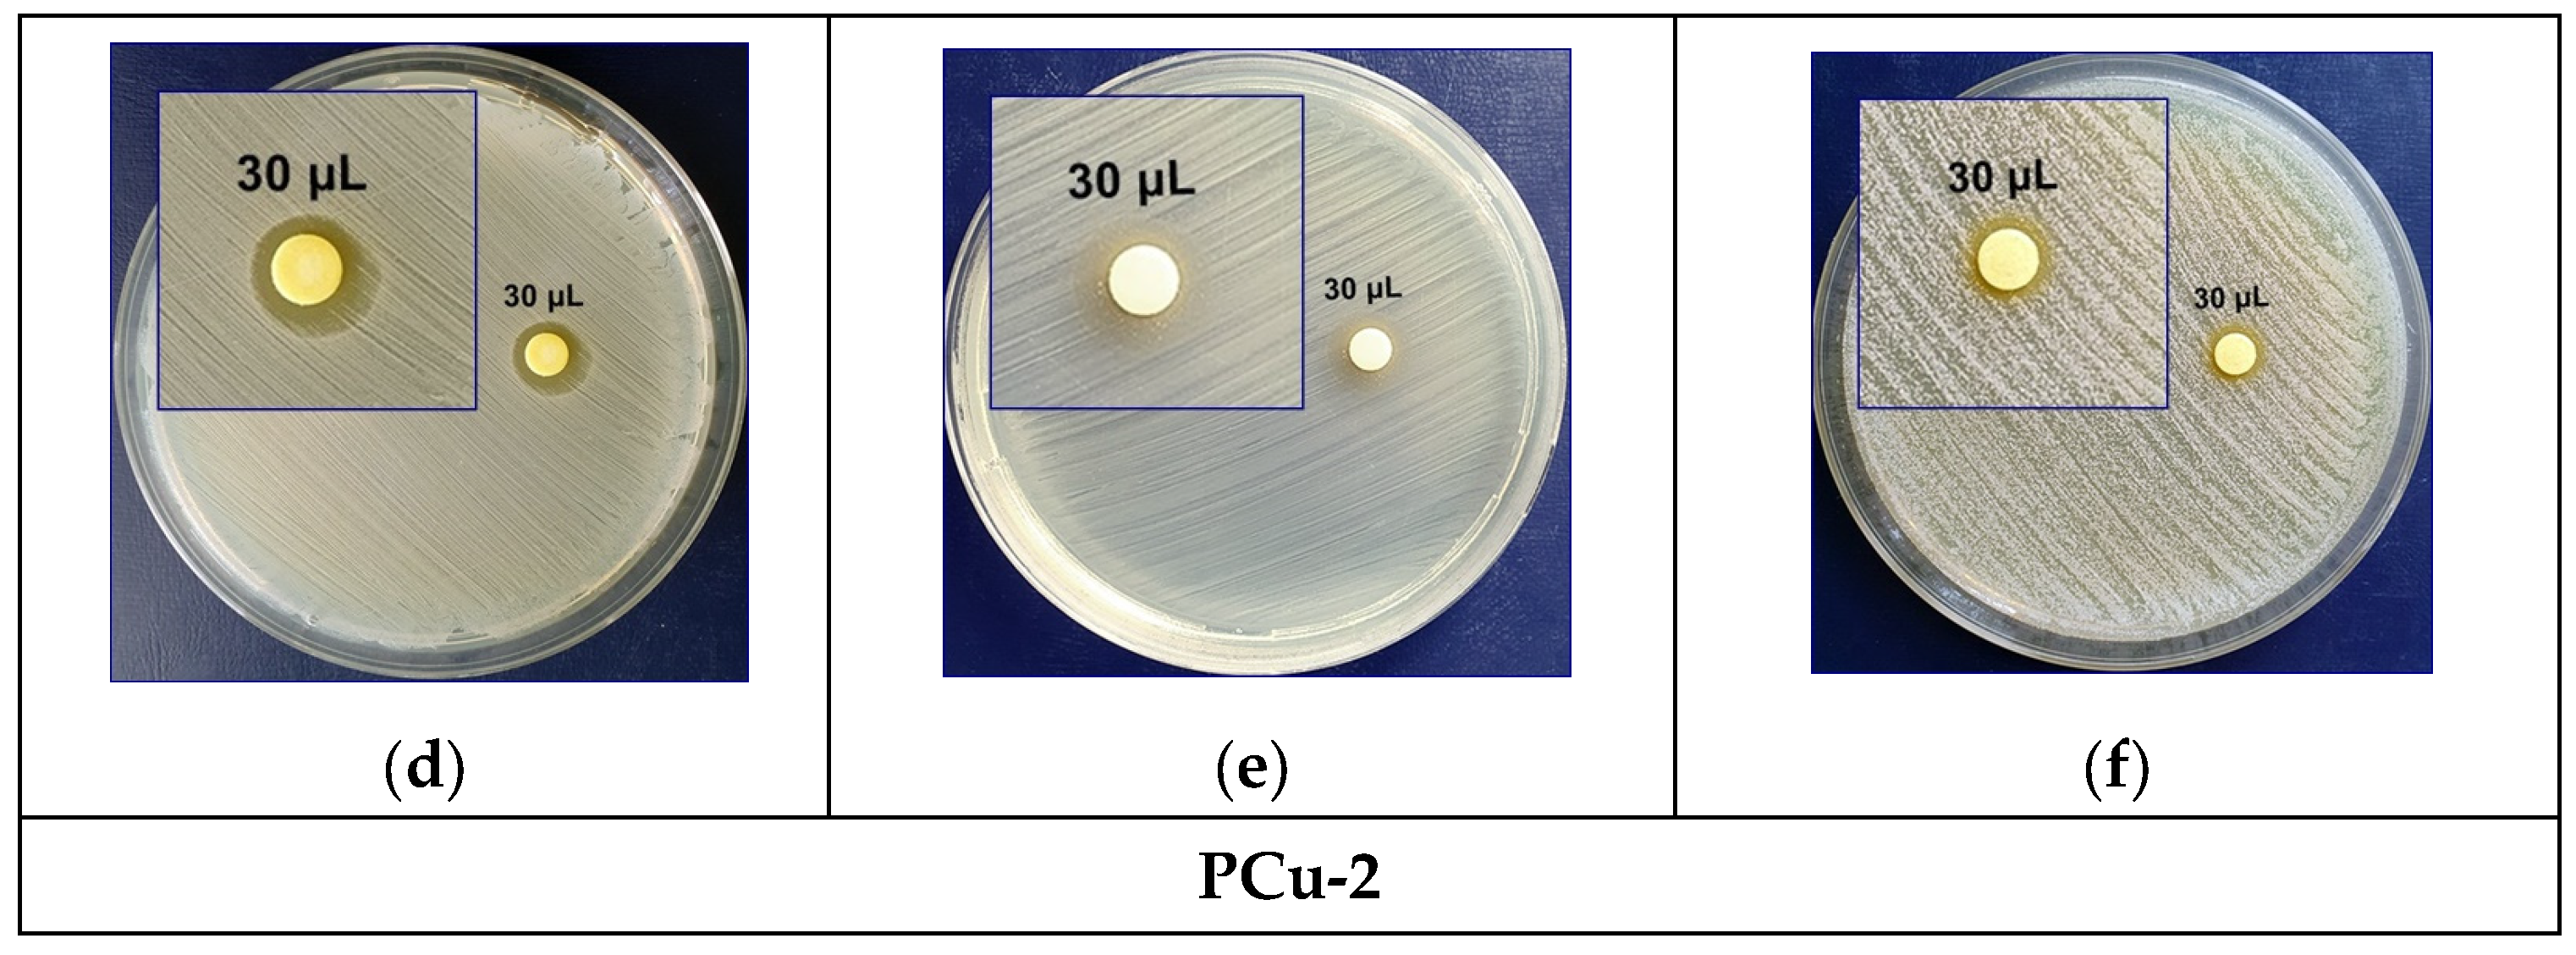
Crystals 14 00659 g011b Crystals 14 00659 g011b

Functionalized Palygorskite as a Delivery Platforms for Bioactive Asymmetric Beta-Diketone Dyes
Abstract
1. Introduction
2. Materials and Methods
2.1. Raw Materials Used for the Modification of the Palygorskite Matrix
2.2. Methods for Obtaining the Carrier Matrices and Loading Them with Curcumin Derivatives
2.3. Structural Characterization Methods
3. Results and Discussion
3.1. Obtaining Organic–Inorganic Hybrid Materials Loaded with Asymmetric Curcumin Analogs
3.2. Structural Characterization of Hybrid Materials as Curcumin Compound Delivery Systems
3.3. Release Study of β-Diketone Derivatives at Variable pH Levels
3.4. Evaluation of the Antimicrobial Activity of Composite Materials
4. Conclusions
Author Contributions
Funding
Data Availability Statement
Acknowledgments
Conflicts of Interest
References
- Lu, Y.; Wang, A. From structure evolution of palygorskite to functional material: A review. Microporous Mesoporous Mater. 2022, 333, 111765. [Google Scholar] [CrossRef]
- Suarez, M.; García-Rivas, J.; Morales, J.; Lorenzo, A.; García-Vicente, A.; García-Romero, E. Review and new data on the surface properties of palygorskite: A comparative study. Appl. Clay Sci. 2022, 216, 106311. [Google Scholar] [CrossRef]
- Wang, W.; Wang, A. Recent progress in dispersion of palygorskite crystal bundles for nanocomposites. Appl. Clay Sci. 2016, 119, 18–30. [Google Scholar] [CrossRef]
- Mo, X.; Zhuang, Z.; Ren, C.; Li, W. Thermal activation of palygorskite for enhanced fluoride removal under alkaline conditions. Appl. Geochem. 2022, 147, 105484. [Google Scholar] [CrossRef]
- Zhang, Y.; Wang, W.; Zhang, J.; Liu, P.; Wang, A. A comparative study about adsorption of natural palygorskite for methylene blue. Chem. Eng. J. 2015, 262, 390–398. [Google Scholar] [CrossRef]
- Song, Y.; Yang, F.; Mu, B.; Kang, Y.; Hui, A.; Wang, A. Phyto-mediated synthesis of Ag nanoparticles/attapulgite nanocomposites using olive leaf extract: Characterization, antibacterial activities and cytotoxicity. Inorg. Chem. Commun. 2023, 151, 110543. [Google Scholar] [CrossRef]
- Zhang, H.; Lu, Y.; Zhang, Q.; Yang, F.; Hui, A.; Wang, A. Structural evolution of palygorskite-rich clay as the nanocarriers of silver nanoparticles for efficient improving antibacterial activity. Colloids Surf. A Physicochem. Eng. Asp. 2022, 652, 129885. [Google Scholar] [CrossRef]
- Zhong, H.; Mu, B.; Yan, P.; Jing, Y.; Hui, A.; Wang, A. A comparative study on surface/interface mechanism and antibacterial properties of different hybrid materials prepared with essential oils active ingredients and palygorskite. Colloids Surf. A Physicochem. Eng. Asp. 2021, 618, 126455. [Google Scholar] [CrossRef]
- Yang, F.; Song, Y.; Ma, M.; Wang, Q.; Liu, Y.; Hui, A.; Wang, A. Incorporation of licorice flavonoids into ZnO/attapulgite nanocomposites for enhanced antimicrobial and antioxidant performance. Mater. Today Commun. 2022, 31, 103478. [Google Scholar] [CrossRef]
- Xu, J.; Sun, Z.; Jia, L.; Li, B.; Zhao, L.; Liu, X.; Ma, Y.; Tian, H.; Wang, Q.; Liua, W.; et al. Visible light sensitized attapulgite-based lanthanide composites: Microstructure, photophysical behaviour and biological application. Dalton Trans. 2011, 40, 12909. [Google Scholar] [CrossRef]
- Hui, A.; Yan, R.; Mu, B.; Kang, Y.; Zhou, Y.; Wang, A. Preparation and Antibacterial Activity of ZnO/Palygorskite Nanocomposites Using Different Types of Surfactants. J. Inorg. Organomet. Polym. 2020, 30, 3808–3817. [Google Scholar] [CrossRef]
- Dong, F.-Q.; Li, G.-W.; Sun, Z.-G.; Shen, G.; Feng, Q.-M.; Dai, Q.-W. Preparation and antimicrobial ability of natural proous antibacterial materials. J. Cent. South Univ. Technol. 2005, 12, 370–375. [Google Scholar] [CrossRef]
- Galan, E. Properties and Applications of Palygorskite-Sepiolite Clays. Clay Miner. 1996, 31, 443–453. [Google Scholar] [CrossRef]
- Da Silva, F.; de Souza, G.P.M.; de Melo Morgado, G.F.; Wearn, Y.N.; Albers, A.P.F.; Quinteiro, E.; Passador, F.R. A Brief Review of the Latest Advances of Attapulgite as a Reinforcing Agent in Polymer Matrix Nanocomposites. Am. J. Eng. Appl. Sci. 2021, 14, 292–307. [Google Scholar] [CrossRef]
- Ferraz, E.; Alves, L.; Sanguino, P.; Santarén, J.; Rasteiro, M.G.; Gamelas, J.A.F. Stabilization of Palygorskite Aqueous Suspensions Using Bio-Based and Synthetic Polyelectrolytes. Polymers 2021, 13, 129. [Google Scholar] [CrossRef] [PubMed]
- Hu, K.; Sun, S.; Wang, Y.; Wang, Y.; Zhang, J.; Zhu, X.; Niu, Y. Preparation and application of Silica Quantum Dots using palygorskite as silicon source. Appl. Clay Sci. 2021, 211, 106132. [Google Scholar] [CrossRef]
- Han, S.; Liu, F.; Wu, J.; Zhang, Y.; Xie, Y.; Wu, W.; Liu, W.; Wang, Q.; Tang, Y. Targeting of fluorescent palygorskite polyethyleneimine nanocomposite to cancer cells. Appl. Clay Sci. 2014, 101, 567–573. [Google Scholar] [CrossRef]
- Fabrícia de Castro, S.; Clécio Brandão, L.L.; Castro, H.L.M.; Pollyana, T.; Anteveli, O.J.; Oliveira, L.A.; Filho, E.C.S. Claysas Biomaterials in Controlled Drug Release: A Scientific and Technological Short Review. Biomed. J. Sci. Tech. Res. 2019, 15, 11237–11242. [Google Scholar] [CrossRef]
- Damasceno Junior, E.; Ferreira de Almeida, J.M.; do Nascimento Silva, I.; Moreira de Assis, M.L.; dos Santos, L.M.; Dias, E.F.; Aragão, V.E.B.; Veríssimo, L.M.; Fernandes, N.S.; da Silva, D.R. pH-responsive release system of isoniazid using palygorskite as a nanocarrier. J. Drug Deliv. Sci. Technol. 2020, 55, 101399. [Google Scholar] [CrossRef]
- Meneguin, A.; Pacheco, G.; Silva, J.M.; Pereira de Araujo, F.; Silva-Filho, E.C.; Bertolino, L.C.; da Silva Barud, H. Nanocellulose/palygorskite biocomposite membranes for controlled release of metronidazole. Int. J. Biol. Macromol. 2021, 188, 689–695. [Google Scholar] [CrossRef]
- Wu, J.; Ding, S.; Chen, J.; Zhou, S.; Ding, H. Preparation and drug release properties of chitosan/organomodified palygorskite microspheres. Int. J. Biol. Macromol. 2014, 68, 107–112. [Google Scholar] [CrossRef] [PubMed]
- Ruggeri, M.; Sánchez-Espejo, R.; Casula, L.; Sandri, G.; Perioli, L.; Cardia, M.C.; Lai, F.; Viseras, C. Bentonite- and Palygorskite-Based Gels for Topical Drug Delivery Applications. Pharmaceutics 2023, 15, 1253. [Google Scholar] [CrossRef] [PubMed]
- Khurana, I.S.; Kaur, S.; Kaur, H.; Khurana, R.K. Multifaceted Role of Clay Minerals in Pharmaceuticals. Future Sci. OA 2015, 1, FSO6. [Google Scholar] [CrossRef] [PubMed]
- Zhang, Z.; Zhang, X.; Fu, Z.; Cao, L.; Xiong, Z.; Tang, Y.; Feng, Y. Fibrous palygorskite clays as versatile nanocarriers for skin delivery of tea tree oils in efficient acne therapy. Int. J. Pharm. 2022, 623, 121903. [Google Scholar] [CrossRef] [PubMed]
- Yao, D.; Yu, Z.; Li, N.; Hou, Y.; Xu, J.; Yang, D. Copper-modified palygorskite is effective in preventing and treating diarrhea caused by Salmonella typhimurium. J. Zhejiang Univ.-Sci. B (Biomed. Biotechnol.) 2017, 18, 474–480. [Google Scholar] [CrossRef]
- Yang, F.; Wang, A. Recent researches on antimicrobial nanocomposite and hybrid materials based on sepiolite and palygorskite. Appl. Clay Sci. 2022, 219, 106454. [Google Scholar] [CrossRef]
- Gad, H.A.; Alshubaily, F.A.; Alsieni, M.A.; Tayel, A.A.; Diab, A.M. Biosynthesis of nano-curcumin/nano-selenium composite and their potentialities as bactericides against fish-borne pathogens. Green Process. Synth. 2022, 11, 1098–1107. [Google Scholar] [CrossRef]
- Zhong, H.; Mu, B.; Zhang, M.; Hui, A.; Kang, Y.; Wang, A. Preparation of effective carvacrol/attapulgite hybrid antibacterial materials bymechanical milling. J. Porous Mater. 2020, 27, 843–853. [Google Scholar] [CrossRef]
- Zhang, X.; Cao, L.; Li, H.; Xiong, Z.; Fu, Z.; Zhang, Z.; Xie, W.; Cui, H.; Zhang, S.; Tang, Y.; et al. Construction of tea tree oil/salicylic acid/palygorskite hybrids for advanced antibacterial and anti-inflammatory performance. J. Mater. Chem. B 2023, 11, 4260. [Google Scholar] [CrossRef]
- Li, S.; Liu, Y.; Zeng, H.; Wang, C.; Han, Z. Dietary Palygorskite-Based Antibacterial Agent Supplementation as an Alternative to Antibiotics Improves Growth Performance, Blood Parameters, and Rumen Microbiota in Sheep. Antibiotics 2023, 12, 1144. [Google Scholar] [CrossRef]
- Meirelles, L.M.A.; Barbosa, R.d.M.; Sanchez-Espejo, R.; García-Villén, F.; Perioli, L.; Viseras, C.; Moura, T.F.A.d.L.e.; Raffin, F.N. Investigation into Brazilian Palygorskite for Its Potential Use as Pharmaceutical Excipient: Perspectives and Applications. Materials 2023, 16, 4962. [Google Scholar] [CrossRef] [PubMed]
- Luciano de Gois da Silva, M.; Fortes, A.C.; Oliveira, M.E.R.; Mendes de Freitas, R.; da Silva Filho, E.C.; Felts de La Roca Soares, M.; Soares-Sobrinho, J.L.; da Silva Leite, C.M. Palygorskite organophilic for dermo pharmaceutical application. J. Therm. Anal. Calorim. 2014, 115, 2287–2294. [Google Scholar] [CrossRef]
- Zhang, Q.; Zhang, H.; Hui, A.; Lu, Y.; Wang, A. Incorporation of Ag NPs/palygorskite into chitosan/glycyrrhizic acid films as a potential antibacterial wound dressing. Results Mater. 2023, 18, 100396. [Google Scholar] [CrossRef]
- Raduly, F.M.; Raditoiu, V.; Raditoiu, A.; Nicolae, C.A.; Grapin, M.; Stan, M.S.; Voinea, I.C.; Vlasceanu, R.-I.; Nitu, C.D.; Mihailescu, D.F.; et al. Half-Curcuminoids Encapsulated in Alginate–Glucosamine Hydrogel Matrices as Bioactive Delivery Systems. Gels 2024, 10, 376. [Google Scholar] [CrossRef] [PubMed]
- Busenberg, E.; Clemency, C.V. Determination of the cation exchange capacity of clays and soils using an ammonia electrode. Clays Clay Miner. 1973, 21, 213–217. [Google Scholar] [CrossRef]
- Raduly, F.M.; Raditoiu, V.; Fierascu, R.C.; Raditoiu, A.; Nicolae, C.A.; Purcar, V. Influence of Organic-Modified Inorganic Matrices on the Optical Properties of Palygorskite–Curcumin-Type Hybrid Materials. Crystals 2022, 12, 1005. [Google Scholar] [CrossRef]
- Kauffman, B.G. Eduard Schweizer (1818–1860): The Unknown Chemist and His Well-Known Reagent. Profiles Chem. 1984, 61, 1095–1097. [Google Scholar] [CrossRef]
- Lin, Y.; Yu, A.; Wang, J.; Kong, D.; Liu, H.; Li, J.; Jia, C. Acurcumin-based AIEE-active fluorescent probe for Cu2+ detection in aqueous solution. RSC Adv. 2022, 12, 16772. [Google Scholar] [CrossRef] [PubMed]
- Silpcharu, K.; Soonthonhut, S.; Sukwattanasinitt, M.; Rashatasakhon, P. Fluorescent Sensor for Copper(II) and Cyanide Ions via the Complexation–Decomplexation Mechanism with Di(bissulfonamido)spirobifluorene. ACS Omega 2021, 6, 16696–16703. [Google Scholar] [CrossRef]
- Xie, H.F.; Yu, C.J.; Huang, Y.L.; Xu, H.; Zhang, Q.L.; Sun, X.H.; Feng, X.; Redshaw, C. A turn-off fluorescent probe for the detection of Cu2+ based on a tetraphenylethylene functionalized salicylaldehyde Schiff-base. Mater. Chem. Front. 2020, 4, 1500. [Google Scholar] [CrossRef]
- Zheng, B.; McClements, D.J. Formulation of More Efficacious Curcumin Delivery Systems Using Colloid Science: Enhanced Solubility, Stability, and Bioavailability. Molecules 2020, 25, 2791. [Google Scholar] [CrossRef] [PubMed]
- Sheikh, J.; Juneja, H.; Ingle, V.; Ali, P.; Hadda, T.B. Synthesis and in vitro biology of Co(II), Ni(II), Cu(II) and Zinc(II) complexes of functionalized beta-diketone bearing energy buried potential antibacterial and antiviral O,O pharmacophore sites. J. Saudi Chem. Soc. 2013, 17, 269–276. [Google Scholar] [CrossRef]
- Hansen, P.E. Structural Studies of β-Diketones and Their Implications on Biological Effects. Pharmaceuticals 2021, 14, 1189. [Google Scholar] [CrossRef] [PubMed]
- Wang, Z.; Zhao, Y.; Shen, M.; Tomás, H.; Zhou, B.; Shi, X. Antitumor Efficacy of Doxorubicin-Loaded ElectrospunAttapulgite–Poly(lactic-co-glycolic acid) Composite Nanofibers. J. Funct. Biomater. 2022, 13, 55. [Google Scholar] [CrossRef] [PubMed]
- Nolan, R.P.; Langer, A.M.; Herson, G.B. Characterisation of palygorskite specimens from different geological locales for health hazard evaluation. Br. J. Ind. Med. 1991, 48, 463–475. [Google Scholar] [CrossRef] [PubMed]
- Kong, Z.-L.; Kuo, H.-P.; Johnson, A.; Wu, L.-C.; Chang, K.L.B. Curcumin-Loaded Mesoporous Silica Nanoparticles Markedly Enhanced Cytotoxicity in Hepatocellular Carcinoma Cells. Int. J. Mol. Sci. 2019, 20, 2918. [Google Scholar] [CrossRef] [PubMed]
- Stern, B.R. Essentiality and Toxicity in Copper Health Risk Assessment: Overview, Update and Regulatory Considerations. J. Toxicol. Environ. Health Part A 2010, 73, 114–127. [Google Scholar] [CrossRef]
- Pérez-Torres, I.; Zúñiga-Muñoz, A.M.; Lans, V.G. Beneficial Effects of the Amino Acid Glycine. Mini Rev. Med. Chem. 2017, 17, 15–32. [Google Scholar] [CrossRef]

| Element | Si | Al | Fe | Mg | K | Ca | Ti | Cu | L.E. |
|---|---|---|---|---|---|---|---|---|---|
| Raw (wt %) | 25.79 (±0.48) | 3.65 (±0.21) | 4.19 (±0.09) | 3.70 (±1.2) | 0.48 (±0.02) | 4.02 (±0.07) | 0.63 (±0.05) | - | 56.74 (±0.9) |
| PCu50 (wt %) | 25.68 (±0.50) | 3.20 (±0.10) | 4.45 (±0.01) | 2.97 (±0.05) | 0.50 (±0.01) | 1.80 (±0.04) | 0.65 (±0.01) | 2.33 (±0.06) | 58.42 (±0.7) |
| Sample | SBET (m2/g) | Vtotal (cm3/g) | pore (nm) |
|---|---|---|---|
| PAL | 117 | 0.327 | 13 |
| P | 36 | 0.319 | 15 |
| PCu30 | 132 | 0.312 | 9 |
| PCu30-1 | 79 | 0.225 | 11 |
| PCu30-2 | 91 | 0.310 | 14 |
| PCu50 | 158 | 0.340 | 9 |
| PCu50-1 | 76 | 0.220 | 12 |
| PCu50-2 | 85 | 0.228 | 16 |
| Element | P Weight % | ACu20 Weight % | ACu30 Weight % | PCu50 Weight % | PCu50-1 Weight % | PCu50-2 Weight % |
|---|---|---|---|---|---|---|
| O | 49.0 (±0.4) | 36.4 (±0.3) | 41.2 (±0.3) | 46.1 (±0.7) | 68.3 (±0.3) | 64.6 (±0.5) |
| Mg | 4.6 (±0.1) | 2.1 (±0.0) | 2.5 (±0.0) | 3.8 (±0.3) | 1.4 (±0.0) | 2.5 (±0.0) |
| Si | 23.7 (±0.2) | 7.8 (±0.1) | 10.3 (±0.1) | 14.9 (±0.7) | 6.0 (±0.1) | 10.8 (±0.1) |
| C | 17.0 (±0.6) | 49.7 (±0.4) | 42.1 (±0.4) | 28.9 (±0.7) | 22.3 (±0.3) | 18.1 (±0.4) |
| Al | 3.4 (±0.1) | 1.6 (±0.0) | 1.9 (±0.0) | 2.7 (±0.2) | 1.0 (±0.0) | 1.9 (±0.0) |
| Fe | 1.3 (±0.1) | 0.7 (±0.0) | 0.7 (±0.1) | 1.6 (±0.3) | 0.4 (±0.0) | 0.7 (±0.0) |
| Ca | 0.5 (±0.0) | 0.7 (±0.0) | 0.3 (±0.0) | 0.6 (±0.1) | 0.1 (±0.0) | 0.3 (±0.0) |
| Na | 1.3 (±0.0) | - | - | - | - | - |
| K | 0.2 (±0.0) | 0.1 (±0.0) | 0.1 (±0.0) | 0.1 (±0.0) | 0.1 (±0.0) | 0.1 (±0.0) |
| Cl | 0.6 (±0.0) | 0.1 (±0.0) | 0.1 (±0.0) | 0.1 (±0.0) | - | - |
| Cu | - | 0.7 (±0.1) | 0.9 (±0.1) | 1.2 (±0.3) | 0.4 (±0.1) | 0.8 (±0.1) |
Disclaimer/Publisher’s Note: The statements, opinions and data contained in all publications are solely those of the individual author(s) and contributor(s) and not of MDPI and/or the editor(s). MDPI and/or the editor(s) disclaim responsibility for any injury to people or property resulting from any ideas, methods, instructions or products referred to in the content. |
© 2024 by the authors. Licensee MDPI, Basel, Switzerland. This article is an open access article distributed under the terms and conditions of the Creative Commons Attribution (CC BY) license (https://creativecommons.org/licenses/by/4.0/).
Share and Cite
Raduly, F.M.; Raditoiu, V.; Raditoiu, A.; Grapin, M.; Fierascu, R.C.; Raut, I.; Constantin, M. Functionalized Palygorskite as a Delivery Platforms for Bioactive Asymmetric Beta-Diketone Dyes. Crystals 2024, 14, 659. https://doi.org/10.3390/cryst14070659
Raduly FM, Raditoiu V, Raditoiu A, Grapin M, Fierascu RC, Raut I, Constantin M. Functionalized Palygorskite as a Delivery Platforms for Bioactive Asymmetric Beta-Diketone Dyes. Crystals. 2024; 14(7):659. https://doi.org/10.3390/cryst14070659
Chicago/Turabian StyleRaduly, Florentina Monica, Valentin Raditoiu, Alina Raditoiu, Maria Grapin, Radu Claudiu Fierascu, Iuliana Raut, and Mariana Constantin. 2024. "Functionalized Palygorskite as a Delivery Platforms for Bioactive Asymmetric Beta-Diketone Dyes" Crystals 14, no. 7: 659. https://doi.org/10.3390/cryst14070659
APA StyleRaduly, F. M., Raditoiu, V., Raditoiu, A., Grapin, M., Fierascu, R. C., Raut, I., & Constantin, M. (2024). Functionalized Palygorskite as a Delivery Platforms for Bioactive Asymmetric Beta-Diketone Dyes. Crystals, 14(7), 659. https://doi.org/10.3390/cryst14070659









